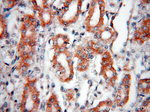
AFG3L2 Antibody in Immunohistochemistry (Paraffin) (IHC (P))

Search
Proteintech
AFG3L2 Polyclonal Antibody
{{$productOrderCtrl.translations['antibody.pdp.commerceCard.promotion.promotions']}}
{{$productOrderCtrl.translations['antibody.pdp.commerceCard.promotion.viewpromo']}}
{{$productOrderCtrl.translations['antibody.pdp.commerceCard.promotion.promocode']}}: {{promo.promoCode}} {{promo.promoTitle}} {{promo.promoDescription}}. {{$productOrderCtrl.translations['antibody.pdp.commerceCard.promotion.learnmore']}}
产品信息
14631-1-AP
种属反应
已发表种属
宿主/亚型
分类
类型
抗原
偶联物
形式
浓度
规格
纯化类型
保存液
内含物
保存条件
运输条件
产品详细信息
Immunogen sequence: ILAGTNRPD ILDPALLRPG RFDRQIFIGP PDIKGRASIF KVHLRPLKLD STLEKDKLAR KLASLTPGFS GADVANVCNE AALIAARHLS DSINQKHFEQ AIERVIGGLE KKTQVLQPEE KKTVAYHEAG HAVAGWYLEH ADPLLKVSII PRGKGLGYAQ YLPKEQYLYT KEQLLDRMCM TLGGRVSEEI FFGRITTGAQ DDLRKVTQSA YAQIVQFGMN EKVGQISFDL PRQGDMVLEK PYSEATARLI DDEVRILIND AYKRTVALLT EKKADVEKVA LLLLEKEVLD KNDMVELLGP RPFAEKSTYE EFVEGTGSLD EDTSLPEGLK DWNKEREKEK EEPPGEKVAN (449-797 aa encoded by BC065016)
靶标信息
AFG3L2 is a protein localized in mitochondria and closely related to paraplegin. The paraplegin gene is responsible for an autosomal recessive form of hereditary spastic paraplegia. AFG3L2 gene is a candidate gene for other hereditary spastic paraplegias or neurodegenerative disorders. This gene encodes a protein localized in mitochondria and closely related to paraplegin. The paraplegin gene is responsible for an autosomal recessive form of hereditary spastic paraplegia. This gene is a candidate gene for other hereditary spastic paraplegias or neurodegenerative disorders.
仅用于科研。不用于诊断过程。未经明确授权不得转售。
生物信息学
蛋白别名: AFG3 ATPase family gene 3-like 2; AFG3 ATPase family member 3-like 2; AFG3 like AAA ATPase 2; AFG3(ATPase family gene 3)-like 2; AFG3-like protein 2; ATPase family gene 3, yeast; FLJ25993; Mitochondrial inner membrane m-AAA protease component AFG3L2; Paraplegin-like protein
基因别名: 2310036I02Rik; AFG3L2; AW260507; Emv66; OPA12; par; SCA28; SPAX5
UniProt ID: (Human) Q9Y4W6, (Mouse) Q8JZQ2
Entrez Gene ID: (Human) 10939, (Mouse) 69597, (Rat) 307350